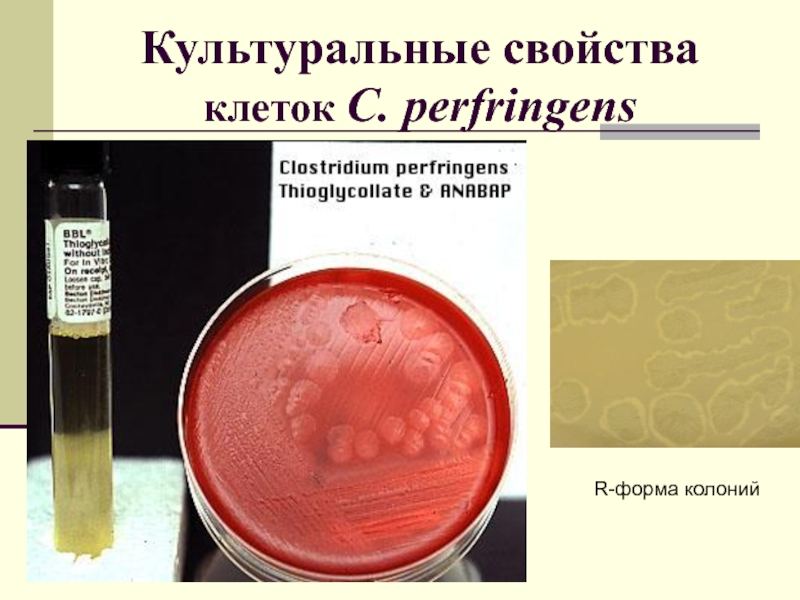

Слайд 1Возбудители анаэробных инфекций
СПбГУ
2014
Слайд 2План лекции
1. Особенности анаэробных инфекций
2. Отличие анаэробных и аэробных МО
3.
Классификация МО по степени толерантности к О2
4. Клинически значимые анаэробные
МО
5. Характеристика Рода Clostridium
6. Возбудители газовой гангрены
7. Вид C. perfringens
8. Вид C. botulinum
9. Ботулотоксин
10. Вид Clostridium tetani
Слайд 3Газовая гангрена -
некроз мягких тканей
Слайд 4Вопрос 1. Особенности анаэробных инфекций
Анаэробная инфекция – эндогенная и экзогенная
инфекция, обусловленная развитием анаэробных микроорганизмов
Слайд 5Разновидности анаэробных инфекций
Экзогенная (раневая) анаэробная инфекция развивается при попадании в
макроорганизм при травмах и ожогах анаэробных споровых микроорганизмов из внешней
среды.
Эндогенная анаэробная инфекция возникает в результате проявления патогенных свойств анаэробными микроорганизмами, входящими в состав нормальной микрофлоры человека.
Слайд 6Вопрос 2.
Отличие анаэробных и аэробных МО
Анаэробы: чувствительны к действию
активных форм кислорода
погибают в присутствии свободных радикалов кислорода
нет ферментов цитохромной
цепи (супероксиддисмутазы (СОД), каталазы)
могут использовать в качестве питательных субстратов органические вещества (углеводы и белки), но в отсутствие кислорода
свойственно брожение или бескислородный тип дыхания
Слайд 72О2- +Н2 СОД Н2О2 + О2 ↑
2 Н2О2 каталаза 2
Н2О+О2↑
Ферменты цитохромной цепи (СОД, каталаза)
Слайд 8Типы брожения и бескислородного дыхания
Брожение:
маслянокислое,
молочнокислое,
пропионовокислое и др.;
Бескислородный
тип дыхания:
сульфатный, нитратный
в этих случаях акцептором ĕ служит
не О2 (как при кислородном дыхании), а сульфаты или нитраты.
Слайд 9Вопрос 3. Классификация анаэробов по степени толерантности к О2
1. Строгие
(облигатные) анаэробы – погибают в течение 1 мин при наличии
в среде свободных радикалов О2. Не растут, если среда содержит 0,5% О2 (напр. метановые бактерии).
2. Аэротолерантные микроорганизмы – выдерживают 1 час при концентрации О2 0,1% (напр. Clostridium perfringens).
Слайд 10продолжение
3. Умеренные анаэробы или микроаэрофилы. Выживают при содержании О2 2-8%,
когда О2 меньше, а СО2 больше -
5-10%.(напр. р.Brucella).
4. Факультативные анаэробы
– растут в присутствии О2 и без него. Для устранения свободных радикалов О2 включают систему цитохромной цепи, образуется каталаза и СОД (напр. все энтеробактерии).
5. Аэробы – только кислородное дыхание (напр. Bacillus, Leptospira).
Слайд 11Вопрос 4. Анаэробные микроорганизмы, имеющие клиническое значение
Слайд 15Вопрос 5.
Характеристика Рода Clostridium
Заболевания: газовая гангрена, столбняк, ботулизм, псевдомембранозный
энтероколит, некротический энтерит
Нормальная микрофлора: ротовая полость, ЖКТ, вагина
Выделяют: 30 видов
при ранениях, ожогах, ампутациях и операциях
Слайд 16Род Clostridium (150 видов)
1.C. perfringens – выявляют в 80% случаев
2.
C. tetani
3. C. botulinum
4. C. septicum
5. C. sordellii
6. C. novyi
7.
C. difficile
Слайд 17Смешанные анаэробные инфекции
ПОЛИКУЛЬТУРЫ:
смесь клостридий разных видов
клостридии и неспорообразующие анаэробы
неспорообразующие анаэробы
и факультативные анаэробы
Слайд 18Морфологические свойства
клеток р. Clostridium
Крупные Гр+ палочки
Ширина 0,6-0,9 мкм
Длина
4-9 мкм
Образуют эндоспоры
при глубоком анаэробиозе
Все клостридии подвижны,
кроме
C.
perfringens
(не имеет
жгутиков)
Слайд 19Локализация спор
р. Clostridium
А -- C. tetani («барабанные палочки»)
Б
-- C. perfringens (различная локализация)
B -- C. botulinum ("теннисные ракетки")
Слайд 20Культуральные свойства клеток р. Clostridium
Питательные среды:
Кровяной анаэробный агар
с глюкозой
Среда Кита-Тароцци
1. Clostridium perfringens
2. Clostridium sporogenes
3. Контроль (незасеянная
среда)
1
2
3
Среда Кита – Тароцци.
Признаки роста - помутнение и газообразование. Показатели протеолиза - почернение и распад кусочков мяса
Слайд 21Культуральные свойства клеток р. Clostridium
1. Незасеянная среда
2. Clostridium perfringens
3. Clostridium
sporogenes
Среда для культивирования сульфитредуцирующих
клостридий. Дифференциация происходит на основании
способности редуцировать сульфит до сульфида,
который с ионами железа образует черный преципитат.
1
2
3
Слайд 22Вопрос 6.
Возбудители газовой гангрены
Газовая гангрена развивается при попадании спор
Clostridium в некротизирующуюся ткань.
Окислительно-восстановительный потенциал (Eh) такой ткани имеет
отрицательный заряд.
Слайд 23Окислительно-восстановительный потенциал (Eh)
Eh некротизирующейся ткани 160-180 mV (микровольт)
Eh нормальной ткани
+150 mV
Редукторы кислорода (тиогликолевая кислота, хлористый цистеин, аскорбиновая кислота) снижают
Eh до -100 mV
Краситель-индикатор ризорцин обесцвечивается при Eh -60 mV
Слайд 24Культивирование анаэробов в микроанаэростатах
микроанаэростат
Контейнер для чашек Петри
Слайд 25
Патогенез газовой гангрены
Развивитие спор Clostridium происходит в некротизирующейся ткани, где:
1. отрицательные значения Eh
2. ферментация углеводов
3. образуются газы, некротизирующий
токсин, гиалуронидаза, ДНК-аза, протеиназы
4. расширение зоны некроза → токсинемия →летальный исход
5. Больного может спасти только специфическая антитоксическая сыворотка!!!
Слайд 26Клинические проявления клостридиальной инфекции
1. некроз ткани
2. токсинемия
3. кишечные инфекции
4. пищевые
отравления
5. некротический энтерит
6. целлюлит
7. воспаление оболочек мышечных тканей и сосудов
8.колонизация
сердечной мышцы, клапанов → эндокардит
Слайд 27Вопрос 7.
Вид C. perfringens
Морфологические свойства клеток
Длина клеток до
8 мкм
Клетки образуют нити
до 140 мкм
образуют субтерминальные
овальные эндоспоры
на
щелочных средах с белками
Неподвижны!!!!!!!!!!!!!!
Слайд 28Культуральные свойства
C. perfringens
Опт.Тº
35-37ºС
рН 7,2-7,4
Через 2-4 ч в ЖПС
бурное
газообразование,
токсинообразование
Колонии 2-5 мм
с зоной гемолиза
Слайд 29Культуральные свойства клеток C.
perfringens
R-форма колоний
Слайд 30Биохимические свойства клеток C.
perfringens
1. ферментируют все сахара с образованием кислоты и газа
2.пептонизируют молоко
3.слабая
протеолитическая активность
(разжижают желатину)
4. растут на 20% желчи и на 2% NaCl,
5. не растут на 6,5% NaCl
Слайд 31АГ свойства, патогенность и токсинообразование C. perfringens
Образуют множество экзотоксинов:
1- главные
токсины
2- минорные токсины
Токсины обладают АГ- специфичностью
Слайд 325 серотипов C. perfringens на основании АГ-специфичности главных экзотоксинов
Слайд 33Минорные экзотоксины
γ – Т1 (гамма) – летальный фактор,
δ –
Т2 (дельта) – летальный фактор и гемолитические свойства,
η – Т3
(эта) – летальный фактор,
θ – Т4 (тэта) – гемолизин,
κ – Т5 (каппа) – коллагеназа, летальный, некротический фактор, действие усиливается в присутствии цистеина,
λ – Т6 (лямбда) – желатиназа, протеиназа, подавляется цистеином,
μ - Т7 (мю) – гиалуронидаза,
ν – Т8 (ню) – дезоксирибонуклеаза (разрушает ДНК)
Слайд 34Диагностика клостридий
Экспресс-диагностика через 2 ч:
1. световая микроскопия:
мазки красят по
Граму и определяют подвижность (в препарате висячая капля).
Обнаружение большого
количества Гр(+) крупных бактерий с обрубленными концами с субтерминальными спорами в совокупности с другими клиническими симптомами дает основание предполагать, что инфекция вызвана бактериями клостридиальной этиологии.
2. ИФА на токсины с сыворотками
Слайд 35Чувствительность клостридий к АМП
Левомицетин
Метронидазол
Клиндамицин
Обязательно проверить на чувствительность к АМП –
культивирование проводят в микроанаэростате (37оС, 4 часа при 1 атм).
Слайд 36Вопрос 8. Вид C. botulinum
Ботулизм – тяжелая токсикоинфекция, характеризующаяся специфическими
параличами
1896 г.
botulus (лат.) - колбаса
Слайд 37Клетка C. botulinum
(позитивное окрашивание, ТЭМ). Жгутики
Слайд 38Морфологические свойства
C. botulinum
клетки Гр+ с закругленными концами, длина
4-9 мкм, образуют субтерминальные и терминальные споры – теннисная ракетка
Жгутики
!!!!
Слайд 39АГ свойства C. botulinum
8 серотипов (деление основано на различии свойств
токсинов):
A – наибольшее значение в США
B – наибольшее значение во
Франции
C1
C2
D
E – наибольшее значение в Японии
F – нет в России
G
Слайд 40Среда обитания C. botulinum
Постоянно споры в воде и почве →
фрукты, овощи → кишечник человека и животных → с испражнениями
в окружающую среду → состояние споры
Нормальная микрофлора ЖКТ животных и рыб
Споры обнаруживают в 9% проб почвы
и 4% проб воды
Слайд 41Культуральные свойства
C. botulinum - строгие анаэробы
Оптимальная температура роста:
Для серотипов
A, B, C, D - 34-35ºC
Для серотипов E, F -
26-30ºC
Токсины частично разрушаются при +80 ºC
Слайд 42Устойчивость спор C. botulinum
Споры серотипов А, В, F- наиболее
устойчивы, разрушаются при кипячении 5-6 час
Хорошо переносят температуру – 16оС
в течение года, могут прорасти и образовать токсины.
Продукты, обсеменение большим числом спор, после размораживания могут оказаться токсичными.
Слайд 43Биохимические свойства
клеток C. botulinum
1. Ферментация сахаров – непостоянный признак
2.
В диагностике исследуют протеолитические свойства:
Серотип А, часть В и F
– обладает сильным протеолитическим действием, остальные ±.
Серотип А – разлагает казеин, Е – не разлагает, остальные ±.
Используют специальные среды, содержащие печень и фарш.
Слайд 44Вопрос 9. Основной патогенетический фактор – экзотоксин (ботулотоксин – нейротоксин)
Протоксин
гидролизуется эндопротеазами.
Токсин состоит из 2-х частей:
L - легкой -
Zn2+-зависимая протеаза (50 кДа) и
Н - тяжелой цепи (100 кДа).
связаны S-S мостиками.
Н-цепь – якорная, прикрепляется к рецептору клетки. L-цепь – осуществляет специфическое блокирование холинэргической передачи возбуждения в синапсах, разрушая везикулы, содержащие ацетилхолин, при этом нарушается передача нервного импульса.
Слайд 45Механизм действия ботулинического токсина (по D. Kedlaya)
Слева-выделение ацетилхолина из
нервного окончания в синаптическую щель при помощи комплекса белков (SNAP-25,
синтаксин, синаптобревин).
Справа - проникновение ботулинического токсина в нервное окончание путем эндоцитоза с образованием токсинсодержащих везикул. В везикулах дисульфидный мостик токсина разрывается, легкая цепь выходит в цитоплазму и расщепляет транспортный белок пресинаптической мембраны SNAP-25, блокируя высвобождение ацетилхолина в синаптическую щель.
Слайд 46Ботулотоксин действует на:
1. двигательные нейроны спинальных моторных центров и продолговатого
мозга, вызывая паралич.
2. периферические двигательные нервно-мышечные рецепторы, нарушая передачу возбуждения
с нерва на мышцу.
Слайд 47Клинические проявления ботулизма
Клинические проявления различны:
1. диспепсия
2. нарушение зрения
3. нарушение дыхания
при
характерных признаках ставят разные диагнозы.
инкуб. период от 12 -
24 час до 10 сут.
летальность 1-60%, РФ – 9%.
чем короче инкуб. период – тем тяжелее заболевание.
Слайд 48Вопрос 10.
Вид C. tetani
Возбудитель раневой анаэробной инфекции - столбняка.
Заболевание характеризуется острым течением, параличом ЦНС – судорогами. В ране
токсин.
Столбняк – «дремлющая» инфекция – очень большой инкуб. период.
От травмы до заболевания может пройти от нескольких дней до нескольких месяцев.
Слайд 49Характерная поза больного столбняком (опистотонус)
Слайд 50Места обитания C. tetani
в норме в испражнениях человека и животных
→ на предметы быта, в раны.
С испражнениями попадает в
почву, где образует споры, попадая из почвы в организм, вызывает заболевания.
Характерная черта C. tetani – локализация в области поврежденной ткани (ранение, ожог, травма).
Остальные виды клостридий быстро распространяются по другим тканям.
Слайд 51Заболевания, вызываемые C. tetani
десен, зубов, среднего уха, возможна контаминация через
иглы.
пупочная культя -
заболевание новорожденных: летальность 40%
летальность обусловлена токсинемией, болеют 2%
новорожденных.
Слайд 52Морфология клеток C. tetani
Молодая культура состоит из длинных одиночных, подвижных
Гр+ палочек,
в старой культуре Гр-.
Образуют круглые терминальные споры
– барабанные палочки.
Слайд 53Морфология клеток C. tetani
"Барабанные палочки"
Слайд 55АГ структура
C. tetani
O- АГ и Н- АГ,
по Н-АГ
выделяют 10 серотипов. Экзотоксин идентичен для всех серотипов.
Слайд 56Культуральные свойства
C. tetani
облигатный строгий анаэроб,
опт.То 35-37оС.
среда выращивания
общая для всего рода.
запах жженного рога + газ.
в ЖПС
– помутнение через 48-72 час,
растет медленнее, чем C. perfringens.
в среде на 2-7 сутки - токсин, потом он разрушается.
Слайд 57Рост C.tetani на ППС
колонии ø 6 мм,
прозрачные серо-желтые,
через
4-6 сут. S и R формы.
в высоких столбиках –
вид чечевицы. гемолиз на кровяном агаре,
не растут в присутствие 20% желчи и
6,5% NaCl.
споры гибнут при 100оС за 1 час.
Слайд 58Биохимические свойства C. tetani
ферментативные (сахаролитические) свойства – не выражены.
образуют протеазы и РНК-азы, разжижают желатин
Слайд 59C. tetani выделяют экзотоксин
→ в ЦНС по лимфо- и кровеносным
сосудам
→ приводит к гиперрефлексии и спазму скелетных мышц -
опистотонус
→ столбняк
Слайд 60Токсины C. tetani
тетанолизин – разрушает эритроциты, обладает летальным действием –
это кардиотоксин.
тетаноспазмин – причина спазмов. Смерть наступает при полном сознании
от асфиксии и поражения жизненно важных центров. Сначала наблюдается тоническое сокращение жевательных и мимических мышц, потом затылка и спины.
Слайд 61Лабораторная диагностика
Материал для исследований: гной, кровь, секционный материал.
Микроскопия, но даже
нахождение Гр+ палочек не дает основания для постановки диагноза, без
определения токсина.
Обязательно! Определение токсина в клиническом материале и культуре.
Диагноз только после проверки сыворотки на мышах.
Слайд 62Профилактика и лечение
профилактика при ранении:
вводят Ig, если не привита
вакцина АКДС или вводят анатоксин
донорский противостолбнячный Ig вводят 1
раз